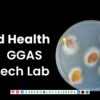

No products in the cart.

Tetrazolium Test Performed in GGAS HI-Tech Lab
The tetrazolium test, also known as the tetrazolium chloride (TZ) test, is a biochemical
experiment used to stain living seed tissues in order to determine the viability of the seed.
According to ISTA, the main principle of using the tetrazolium test is to indicate viability difference between seed lots is the same as when using the test to estimate seed viability.
PROTOCOL:
- Utilized ISTA standardized protocols the test is carried out on two replicates of 100 pure seeds each replicate.
- Seeds are imbibed in water for prescribed time.
- Seeds are dissected in sterilized conditions.
- The intact imbibed seeds are placed in a 0.1% 2,3,5-triphenyl tetrazolium chloride solution at the prescribed temperature and time.
- The seeds are completely immersed in the staining solution.
- Each seed is examined and classified into viable and non-viable categories.
BENEFITS:
- The tetrazolium test according to ISTA guidelines benefits farmers by quickly assessing seed viability, allowing for better seed selection and planting decisions.
- It helps identify non-viable seeds before planting, reducing waste and improving crop yields.
- This test also provides early insight into seed quality, ensuring more consistent and reliable crop establishment.